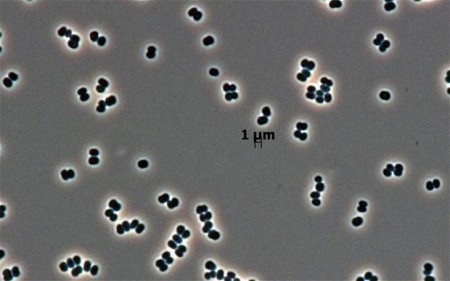

A NASA-nak nem is kell feltétlenül távoli égitestekre űrszondákat küldeni, hogy új mikrobiális életformát fedezzen fel. Elég körülnézni „otthon”, a tisztaszobában!
Ezeket a helyiségeket éppen arra használják, hogy bennük az űreszközöket a lehető legsterilebb körülmények között készítsék fel az utazásra. Ha például egy idegen bolygó felszínére küldenek űrszondát, adott esetben akár az ott fellelhető életformák nyomainak kimutatására, akkor nagyon fontos, hogy lehetőleg ne hurcoljanak be ilyeneket a Földről. Ennek érdekében a tisztaszobákban számos elővigyázatossági intézkedést tesznek. A helyiségeket rendkívül szárazon tartják, rendszeresen vegyi anyagokkal fertőtlenítik, ultraibolya sugárzással és hőkezeléssel sterilizálják, levegőjüket szűrik. A légnyomás magasabb a normálisnál, így a ki- és bemenet során a kifelé áramló levegő miatt sem tudnak mikroorganizmusok bejutni. A bent dolgozó munkatársak természetesen speciális védőruhát viselnek.
Rutinszerű mikrobiológiai mintavétel a NASA Jet Propulsion Laboratory (JPL) tisztaszobájának padlójáról. (Kép: NASA)
Az óvintézkedések és az élőlények számára mostoha körülmények ellenére a tisztaszobából időnként mintát vesznek, hogy megvizsgálják az ott esetleg előforduló mikrobákat. Ennek akkor lehet igazán jelentősége, ha egy távoli égitestre küldött műszer találna „valamit”. Ilyenkor az eredményeket össze lehet vetni a földi ellenőrző adatokkal, hogy teljesen kizárják: valami itthonról odavitt életnyom játszhat közre a „felfedezésben”.
Ilyen vizsgálatok során találták meg azt az igen ellenálló baktériumot, amely annyira különleges, hogy nem csak egy új faj, de egy eddig ismeretlen nemzetség képviselője is. A neve Tersicoccus phoenicis, arra is utalva, hogy a NASA Phoenix Mars-szondájának földi előkészítése során vett mintákban találták meg először. A felfedező kutatócsoport szakmai beszámolója az International Journal of Systematic and Evolutionary Microbiology című folyóiratban látott napvilágot. Ráadásul az új baktérium nem csak a NASA floridai Kennedy Űrközpontjában, de attól távol, egy másik űreszköz-előkészítő tisztaszobában, az ESA francia guyanai Kourou űrközpontjában is felbukkant. Feltételezik persze, hogy természetes környezetben is előfordul, de ott a rengeteg egyéb mikroorganizmus mellett nehezebb kimutatni. A tisztaszobákban azonban gyakorlatilag mindent kiirtanak mellőle, a Tersicoccus phoenicis viszont a jelek szerint ellenáll a sterilizálási kísérleteknek.
A Tersicoccus pheonicis baktériumok felnagyított képe. Az összehasonlító skála 1 μm-t mutat. (Kép: NASA / JPL-Caltech)
A nagyjából 1 mikrométeres baktérium a jelek szerint lényegében táplálék nélkül elél. Felfedezése azért is fontos, mert ha a tisztaszoba körülményeit ilyen jól átvészeli, akkor arra is nagyobb lehet az esélye, hogy túléljen akár egy bolygóközi utazást. A Tersicoccus phoenicis viselkedésének kutatása ezért folytatódik.
Kapcsolódó cikkek: Kapcsolódó linkek:
Csak legenda a holdutazást túlélő baktériumok története
Baktériumok a csillagközi térbe?
Űrhajósjelölt baktériumok?
A Marsra érkezett a Phoenix
Megvan a marsi víz
Leállt a Phoenix
Megvoltak az élet feltételei a Marson
Terv az Europa jégpáncéljának in situ vizsgálatára
Új baktérium a NASA tisztaszobájából (The Telegraph)

 Egy az eddig ismertektől alapvetően eltérő biokémiai megoldást alkalmazó élőlényt fedeztek fel a Földön: egy olyan baktériumot, amely foszfor helyett arzént is tud használni szerves molekuláinak, például DNS-ének felépítésénél.
Egy az eddig ismertektől alapvetően eltérő biokémiai megoldást alkalmazó élőlényt fedeztek fel a Földön: egy olyan baktériumot, amely foszfor helyett arzént is tud használni szerves molekuláinak, például DNS-ének felépítésénél. 


